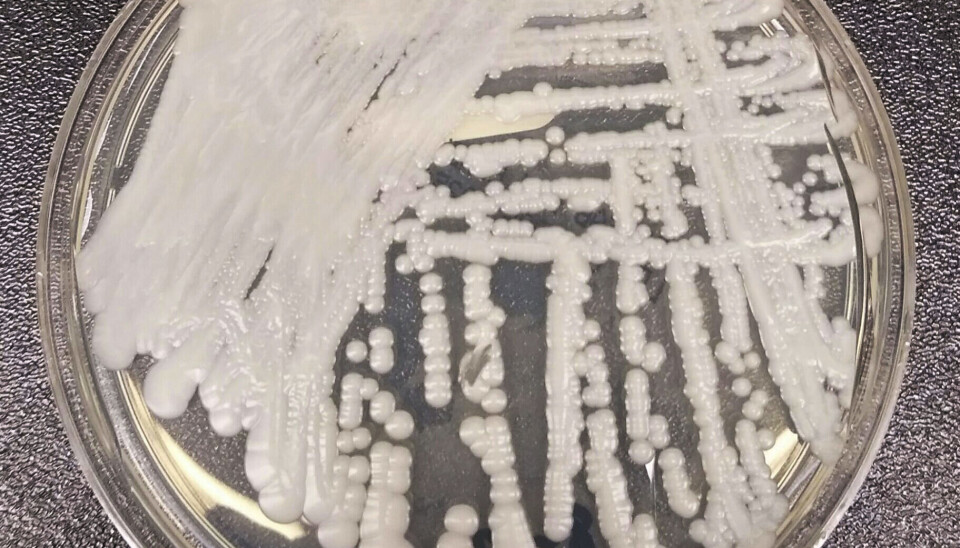

Smittevernbyrå melder om dødelig gjærsopp på sykehus i Europa
Gjærsoppen Candida auris kan forårsake en dødelig infeksjon og har spredt seg raskt på sykehus i Europa. I Norge er den sjelden, men FHI følger nøye med.
Candida auris er ofte forkortet C. auris. Det første utbruddet ble oppdaget på et sykehus i Valencia i Spania i 2016.
Nå advarer Det europeiske smittevernbyrået (ECDC) i en fersk rapport , gjengitt av TV 2.
Fra 2013 fram til 2023 ble det bekreftet 4012 tilfeller av soppen i Europa, en tredel av tilfellene ble oppdaget i 2023 alene. ECDC frykter mørketall.
Selv om forekomsten øker i Europa, er gjærsoppen fortsatt sjelden i Norge, ifølge Folkehelseinstituttet (FHI). I fjor var det seks tilfeller, mens det hittil i år er meldt om to.
– Pasienter med nedsatt immunforsvar er særlig utsatt, og det har vært en økende bekymring knyttet til medikamentresistens for nettopp denne arten, sier Espen Rostrup Nakstad, leder for Nasjonal behandlingstjeneste for CBRNE-medisin ved Oslo universitetssykehus.
– Det er spesielt kritisk syke pasienter som er utsatt for infeksjon med C. auris, og derfor ønsker vi ikke at den skal spre seg i sykehus, sier overlege Miriam Sare ved FHI, som har bidratt til rapporten for Norge.